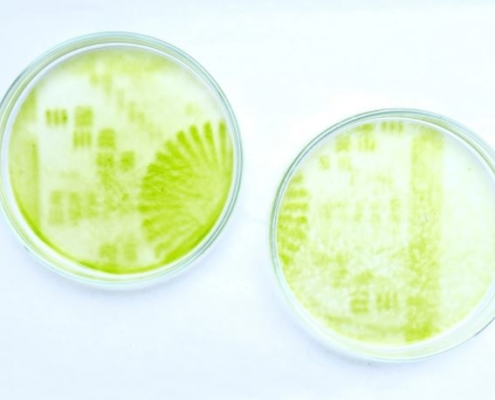

https://www.knowledgequarter.london/wp-content/uploads/2022/05/CSM-graduate-show.jpg
1273
2000
Jodie Eastwood
https://www.knowledgequarter.london/wp-content/uploads/2016/03/kq-icon-2016.png
Jodie Eastwood2022-05-23 12:27:532022-05-23 12:27:53KQ Private View: Central Saint Martins Degree Show
https://www.knowledgequarter.london/wp-content/uploads/2022/05/CSM-graduate-show.jpg
1273
2000
Jodie Eastwood
https://www.knowledgequarter.london/wp-content/uploads/2016/03/kq-icon-2016.png
Jodie Eastwood2022-05-23 12:27:532022-05-23 12:27:53KQ Private View: Central Saint Martins Degree Show https://www.knowledgequarter.london/wp-content/uploads/2022/05/CSM-graduate-show.jpg
1273
2000
Jodie Eastwood
https://www.knowledgequarter.london/wp-content/uploads/2016/03/kq-icon-2016.png
Jodie Eastwood2022-05-23 12:27:532022-05-23 12:27:53KQ Private View: Central Saint Martins Degree Show
https://www.knowledgequarter.london/wp-content/uploads/2022/05/CSM-graduate-show.jpg
1273
2000
Jodie Eastwood
https://www.knowledgequarter.london/wp-content/uploads/2016/03/kq-icon-2016.png
Jodie Eastwood2022-05-23 12:27:532022-05-23 12:27:53KQ Private View: Central Saint Martins Degree Show
KQ Masterclass: Managing Stress with CANDI NHS Foundation Trust
Join us for a masterclass in managing stress at work, in partnership with C&I Wellbeing Partnerships, of Camden and Islington NHS Foundation Trust.

KQ Private View: The World of Stonehenge
In this special private view of their blockbuster exhibition, the British Museum will reveal the secrets of Stonehenge, shining a light on its purpose, cultural power and the people that created it.
KQ CLIMATE ACTION: Algae Materials and Ecosystems
Students from Central Saint Martins MA in Biodesign will lead this hands-on workshop at the Somers Town Living Centre about why and how living organisms can be transformed into new plant-positive materials.

KQ Private View: Superheroes, Orphans & Origins: 125 years in comics
This spring, the Foundling Museum presents the first major exhibition to explore the representation of foundlings, orphans, adoptees, and foster children in comics. Join us for a private view exploring over a century of mainstream comics, graphic novels and sequential art from around the world.
 © Scott Graham/Unsplash
© Scott Graham/UnsplashKQ Policy and Public Affairs Network: Levelling Up
For this special event brought to you in partnership with GuildHE, policy and public affairs experts from across the Knowledge Quarter will present their response to the Government's Levelling Up white paper, to discuss what it means for Kings Cross, London, and beyond.

Income Inequality in the Knowledge Quarter
According to the latest ONS Household Finances Survey, the gap between the richest in society and the rest of the population has widened over the last 10 years. For this special conference legacy event, a panel of economists and policy experts will discuss the causes and impacts of pay and income inequality on KQ organisations and the area they call home.

KQ Private View: Slade 150
While we have to take a break from our in-person private views, we are working with curators to bring the KQ’s cultural offering to the digital realm! Join us at 3pm on Wednesday 9th March for an online experience brought to you by the UCL Slade School of Fine Art and UCL Culture.

KQ Masterclass: Mental Health and Wellbeing of your Workforce
Join us for a masterclass in talking with colleagues and managers about mental health and wellbeing at work, in partnership with C&I Wellbeing Partnerships, of Camden and Islington NHS Foundation Trust.
Contact us
Alternatively, please call
Jodie Eastwood on 020 7412 7116